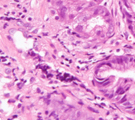

内視鏡 3-b リンパ球プラズマ細胞性十二指腸炎の犬の1例
| ポメラニアン、メス、7歳4ヶ月。体重3.0kg。てんかんありフェノバール1/2錠POq12hにて管理中。「昨日より1日中嘔吐が続いて何も食べない。発作もあった」とのことで夜間救急来院。 | |||
 |
 |
|
 |
| 胃幽門部内視鏡所見。結節状隆起あり。 | 十二指腸内視鏡所見。充血と粗造感あり。 | 幽門部結節部組織所見。結合組織増生と炎症細胞浸潤あり。 | 十二指腸粘膜組織所見。固有層にリンパ球、プラズマ細胞の浸潤あり。 |
| 経過:2日間対症的に静脈輸液とH2ブロッカーの投与を行なったが、やはり食事投与直後に苦しそうな嘔吐が1日1回続いた。上腹部X線所見で胃粘膜肥厚が認められたので、上部消化器内視鏡検査を施行した。幽門部に結節状隆起部、十二指腸粘膜に著明な充血および粗造感がみられ、それぞれ内視鏡下生検を行なった。幽門部粘膜の間質には慢性炎症細胞浸潤を伴った高度の線維化が認められ慢性萎縮性胃炎の組織所見が得られ、十二指腸粘膜固有層には、リンパ球およびプラズマ細胞の軽度の浸潤が認められた。十二指腸の腺部の間隙はタンパク漏出性様に解離しており機能的問題がある可能性が病理医より指摘された。治療経過中、ALB 1.9mg/dlと低値が観察されやや軟便であったので、膵外分泌機能不全も疑ったがTLI 10.2 ng/ml(基準5.0-35.0)で正常であった。最終的に慢性萎縮性胃炎を伴ったリンパ球プラズマ細胞性十二指腸炎と診断した。再度問診にて数ヶ月前よりHill'sのフードから市販フードに変更していたことを確認した。小腸疾患用の食事(CIW)、サラゾピリン、H2ブロッカーを10日間処方し、嘔吐は消失し便の状態も改善した。以降は食事を元のHill'sのフードに戻し、処方の必要なく良好に経過している。 | |||
| コメント:リンパ球プラズマ細胞十二指腸炎は、どうも食事に関連して起こることが多いようです。 | |||